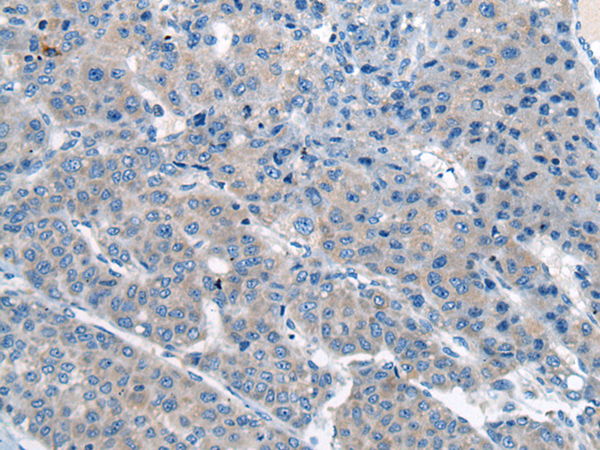

-
分类: 科研抗体货号: P13069别名: CEP123; CCDC123应用: IHC反应种属: Human, Mouse
-
分类: 科研抗体货号: P13089别名: CKS1; ckshs1; PNAS-16; PNAS-18应用: IHC反应种属: Human, Mouse
-
分类: 科研抗体货号: P13068别名: CEP27; C15orf25; HsT17025应用: WB,IHC反应种属: Human, Mouse
-
分类: 科研抗体货号: P13088别名: CKSHS2应用: IHC反应种属: Human, Mouse
-
分类: 科研抗体货号: P13067别名: KAB; FAM68A; KIAA0470应用: WB,IHC反应种属: Human, Mouse
-
分类: 科研抗体货号: P13087别名:应用: IHC反应种属: Human
-
分类: 科研抗体货号: P13098别名: CST-1; CSTN1; CDHR12; PIK3CD; ALC-ALPHA; XB31alpha; alcalpha1; alcalpha2应用: IHC反应种属: Human, Mouse, Rat
-
分类: 科研抗体货号: P13086别名: ASD8; MRG1; VSD2; MRG-1; P35SRJ应用: IHC反应种属: Human, Mouse
-
分类: 科研抗体货号: P13096别名: DFNB81; PRLTS3应用: WB反应种属: Human, Mouse
-
分类: 科研抗体货号: P13085别名: MSG1应用: WB,IHC反应种属: Human, Mouse

鄂公网安备42018502007531号
鄂公网安备42018502007531号

